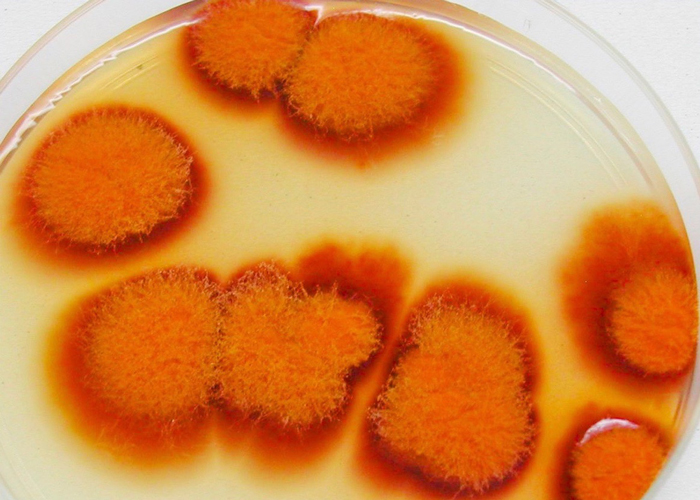

Reactive surfaces
It is customary to try and start the year with a rejuvenated approach, a fresh perspective, a healthy dollop of hope, and plenty of plans. Like so many, I began last year in this manner, only to find us all in the strangest of circumstances merely weeks into proceedings. Sadly, it cannot be said that the dawning of 2021 comes with substantial change or stability, yet. But if we push beyond the front-page news, there are signs of hope to be found in the world of material development.

Given our collective experiences these past 12 months, it seems apposite to first look at material developments that tackle an on-going issue that has come into sharper focus than ever before: the cleanliness of our surfaces. Whilst the research surrounding how COVID-19 reacts to different surfaces continues to unfold, it is understood that it acts in a similar way to other coronaviruses and causes some risk should someone come into contact with a contaminated surface. Beyond the novel coronavirus itself, there will undoubtedly remain a lingering apprehension in some when it comes to interacting in public spaces for years to come. And whilst antibacterial sprays and gels have become a fairly permanent fixture of our daily lives, we all long for a time when we don’t carry the fear of possibly deadly repercussions should there not be any available to us. So what if our surfaces could do the job of the sanitisers for us? It has long been known that copper has antimicrobial properties that stop microorganisms from growing on its surface, but Italian ceramic tile brand Marazzi has taken this a step further in creating antibacterial surface coverings. Their Puro technology works via a silver ion additive that is included in the ceramic mix before firing and therefore offers intrinsic hygiene to a range of stunning wall and floor tiles. So as well as all the usual benefits of large format ceramic tiles, Puro ranges such as Carácter and Alba also eliminate up to 99.9% of bacteria and other germs.

And as if that wasn’t enough to get excited about, tiles of the near future may also do more than kill bacteria. Mumbai-based Carbon Craft Design has developed a new range of tiles that actually upcycle carbon emissions. Carbon Tile specifically upcycles pyrolysis carbon waste that would ordinarily be burnt in bulk quantities. As Carbon Tile project Leader Giriprashad K explains:
“Low-value carbon waste that is generated at tyre pyrolysis factories usually ends up at brick and cement kilns and is burnt to produce heat. As a result, the air quality of the cities around these factories is affected, but as there is no alternate value for this recovered carbon from these pyrolysis setups, the process keeps on going at an uncontrolled rate. India alone produces over half a million tons of this carbon waste annually and at present, it is only burnt which causes masses of air pollution.”

The main causes for this can be attested to the building & construction industry, which is the largest consumer of raw materials and responsible for 39% of total energy-related carbon emissions according to the World Green Building Council. In creating Carbon Tiles this carbon waste is locked in and what’s more, it can be used by the very same industry when applying surfaces to the interiors of these build environments.
Of course, so much of the carbon we create comes as a result of the manner in which we produce our power, and there are alternatives to fossil fuels. Surfaces that create a photoelectric effect; a process where solar energy in the form of light is transformed into electric current, are certainly not a new invention. In fact, the first solar cell was created as long ago as 1883, when American inventor Charles Fritts applied selenium to a thin layer of gold. True, his device was said to offer only 1% efficiency, but it paved the way for a great number of scientific discovers in the photoelectric effect and led to a surge in material developments. Many great minds have applied themselves to such research, not least Albert Einstein, who was awarded the Nobel Prize in Physics for his part in the process exactly 100 years ago. His findings led to the discovery of the photovoltaic effect; a process that uses semiconducting materials such as crystalline silicon to convert light into electricity. As the space race picked up speed in the second half of the last century, solar cells were being deployed to power both spacecraft and domestic calculators, and by the 1990s solar panels were first installed on roofs as a sustainable alternative source of power.

Robert Coelius, University of Michigan
Here in the 21st century, there is a vast range of solar panels available at both domestic and commercial scale, with variations in materials, thickness, weight, and efficiency aplenty. The most efficient range between 30-50% but they share the same characteristic as all solar panels – opacity. For whilst glass is often deployed in the manufacturing of solar panels it is generally there to sandwich the reactive photovoltaic materials, which generally derive from silicon. But a team of researchers at the University of Michigan have now set a new efficiency record for colour-neutral, transparent solar cells. The 8.1% efficiency may be substantially lower than the top performers out there, but with a 43.3% level of transparency, there is great potential in this new surface material. Just imagine a glass skyscraper that provides power by simply being a skyscraper made of glass.

Robert Coelius, University of Michigan
As led professor Stephen Forrest points out, “Windows, which are on the face of every building, are an ideal location for organic solar cells because they offer something silicon can’t, which is a combination of very high efficiency and very high visible transparency,”

The sequestering of carbon doesn’t just have to focus upon waste though. Design duo Post Carbon Lab have turned their attention to textiles and created carbon capturing surfaces by utilising the ultimate carbon capturing process: photosynthesis. Second-hand textiles are coated with photosynthetic microbes and these microorganisms readily carry out the carbon cycle, whilst also dyeing the fabrics in varying green shades. And of course, with photosynthesis comes the generation of oxygen, and the team believes that a surface the size of a T-shirt treated in this way acts in the same way as a small tree.

The ways in which we produce our textiles has come under increased scrutiny over the past few years and the process of dyeing fabric has been highlighted as a particularly problematic element. Industry standards have generally favoured artificial colour and applications of those colours involve masses of water and with it, a surplus of contaminated wastewater. Natural dyes are most definitely not a novel idea, but with this reconnection to organic possibilities come new explorations, notably with the use of fungi.
Through careful experimentation, designer Ilse Kremer has identified Monascus Purpureus and Ashbya Gossypii as the ideal fungi to create add colour to textiles. Once established under controlled conditions the fungi can be dissolved in solvents and the resulting dye can be added to water and applied to fabric. Whilst further experimentation is underway to help understand how varying fabrics respond to the process, a number of consistent colours have already been created and Kremer has noted that some fungi have the potential to colour wood.
So, as we begin to think about a life without lockdowns and a global pandemic, we can also begin to imagine spaces with surfaces that react to some of the most pressing issues of our time; namely the welfare of people and the planet.








